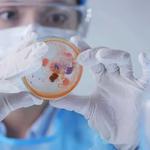
Glover Environmental | Mold Removal & Remediation Apex NC - photo 4

Glover Environmental | Mold Removal & Remediation Apex NC
About Business
We provide Mold Inspection and Mold Removal to Residential and Commercial Clients throughout the Raleigh-Durham areas. Our services include Mold Inspections, Indoor Air Quality Testing, Material Sample Testing, Real Estate Mold Inspections, Mold Identification, Mold Removal Contracting Services, Mold Remediation, Mold Removal, and Accredited Lab Reports.
Other Businesses

Damage Restoration
Regent Restoration

Damage Restoration
Spokane Mold Removal Solutions

Damage Restoration
Patriotic Capital Water Damage Experts

Damage Restoration
Water Damage & Restoration Club Chula Vista

Damage Restoration
Emergency Response Team

Damage Restoration
Disaster Plus Corp

Damage Restoration
Flood Damage Restoration Griffith

Damage Restoration